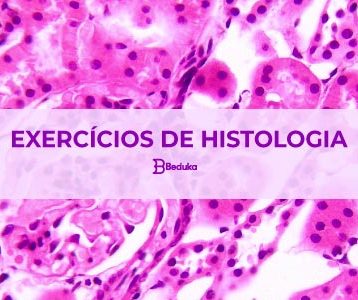

O Sistema Digestório é responsável pela digestão dos alimentos e absorção dos nutrientes. Os principais órgãos...
Exercícios
Magnetismo é a capacidade de um objeto atrair outros objetos, por meio da propriedade de atração...
Exercícios sobre biomas brasileiros com Resumo, características e Gabarito! Servem para alunos do 6º,7º,8º e 9º
A Bioquímica é o estudo sistemático das biomoléculas e de todos os sistemas biológicos, bem como...
Histologia é o estudo dos tecidos biológicos. Os tecidos são formados por células que possuem funções...
República Velha é a denominação dada ao período histórico brasileiro que se estendeu da Proclamação da...
A probabilidade é um conceito na matemática que calcula possibilidade de um certo evento ocorrer ....
Progressão geométrica (PG) é uma sequência numérica em que a razão (q) entre um termo e...
Teste seus conhecimentos para o ENEM e outros vestibulares resolvendo alguns exercícios sobre gêneros literários! Revise
Não sabe como estudar as figuras de linguagem para o Enem e outros vestibulares? Faça alguns...
A eletroquímica é uma parte da química que estuda as reações de oxirredução e a transferência...
Cinética química é uma área que estuda a velocidade das reações químicas e os fatores que...